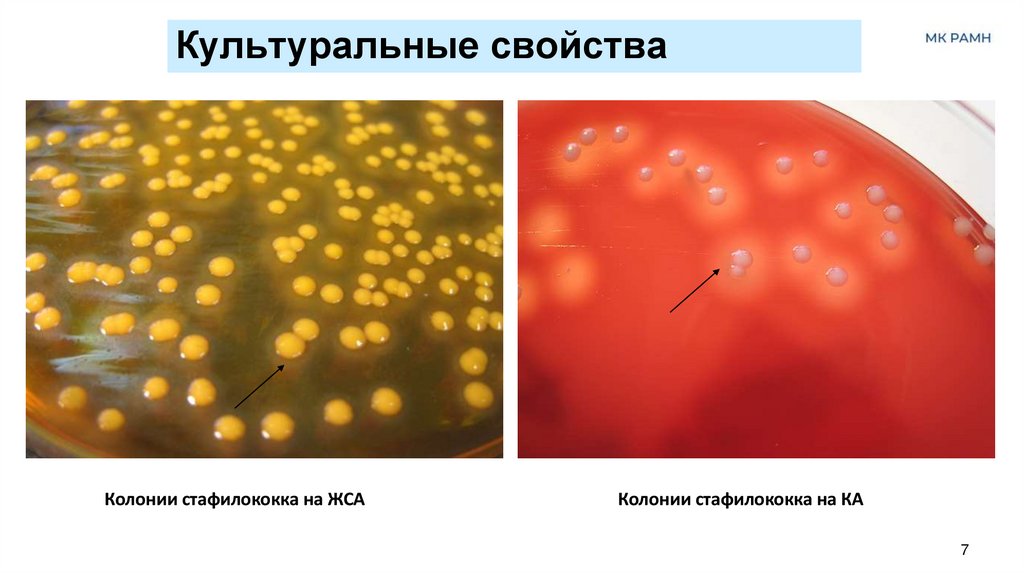
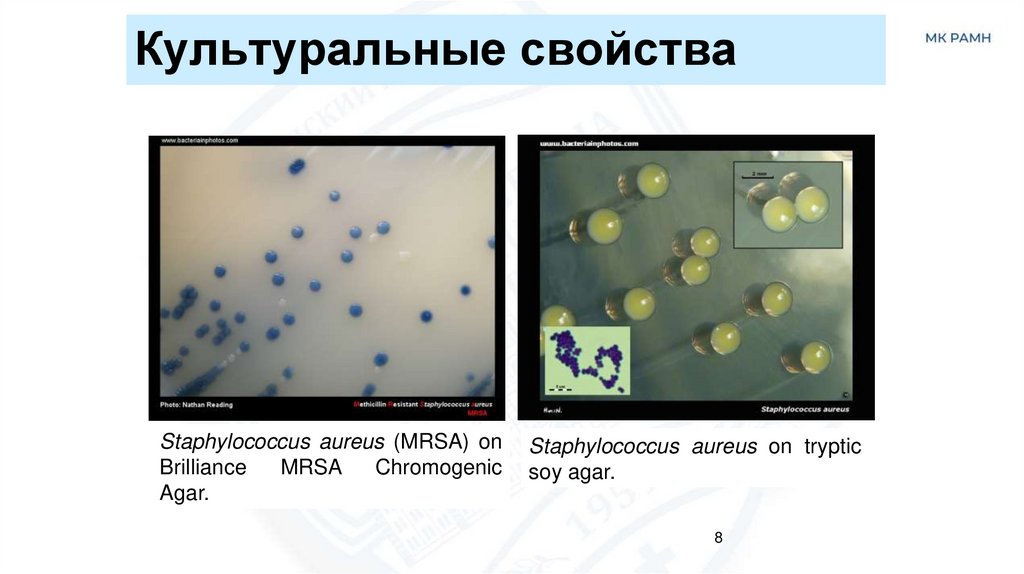

Similar presentations:
Бактерии рода Staphylococcus (1)
1.
Возбудители гнойновоспалительныхзаболеваний
Патогенные кокки
2.
Общая характеристика возбудителей кокковых инфекцийКлассификация Берги
• семейство Staphylococcaceae
(род Staphylococcus)
• семейство Streptococcaceae
(род Streptococcus)
• семейство Neisseriaceae
(род Neisseria: гонококк и менингококк)
Основное значение в патологии человека имеют:
• Staphylococcus aureus (золотистый стафилококк)
• Streptococcus pyogenes (пиогенный стрептококк)
• Neisseria meningitis (менингококк)
2
• Neisseria gonorrhoeae (гонококк)
3.
Общие признаки патогенных кокков• вызывают гнойно-воспалительные процессы
разной локализации (гноеродные или
пиогенные кокки)
• неподвижны, не образуют спор
• тинкториальные свойства: грам+ (стафилококк
и стрептококк) и грам- (менингококк и гонококк)
• культуральные и биохимические свойства:
Стафилококки – наименее требовательны к
средам, биохимически более активны
Гонококки – наиболее требовательны к средам,
биохимически менее активны
3
4.
СтафилококкиКлассификация:
• Семейство: Staphylococcaceae
• Род: Staphylococcus (31 вид)
• Основные виды:
1. S.aureus – коагулазоположительный золотистый
стафилококк (основной патогенный вид);
2. S.epidermidis – коагулазоотрицательный
эпидермальный стафилококк;
3. S.saprophyticus – коагулазоотрицательный
сапрофитический стафилококк
4
5.
Морфология стафилококков• Имеют шаровидную
форму, диаметром 0,5-1,5
мкм
• Грам+ кокки, в мазках
располагаются виде
(“staphylo”) гроздевидных
скоплений
• Спор не образуют,
обычно не имеют
капсулы
• Клеточная стенка
содержит пептидогликан
и тейхоевые кислоты,
белок А (S.aureus)
5
6.
Культуральные свойства• Факультативные анаэробы,
t - 37o С, время: 18-24 ч., pH:7,2 – 7,6
• Растут на неселективных питательных средах:
(МПБ, МПА, кровяном МПА)
элективной среде (ЖСА: до 15% NaCl + желток)
• На МПА/ЖСА - колонии гладкие, выпуклые с ровными
краями размером 1- 4 мм (белые, золотистые, жёлтые),
окружены зоной лецитиназной активности (радужный
венчик)
• На кровяном мясопептонном агаре – полупрозрачные
или белые колонии, окруженные зоной гемолиза
• На мясопептонном бульоне - диффузное помутнение
6
7.
Культуральные свойстваКолонии стафилококка на ЖСА
Колонии стафилококка на КА
7
8.
Культуральные свойстваStaphylococcus aureus (MRSA) on
Brilliance
MRSA
Chromogenic
Agar.
Staphylococcus aureus on tryptic
soy agar.
8
9.
Биохимические свойства• Каталаза+ (отличие от стрептококков)
• Сахаролитические свойства: расщепляют углеводы
(глюкоза, лактоза, мальтоза, сахароза, глицерин) в аэробных
и анаэробных (S.aureus) условиях до кислоты
• Протеолитические свойства: растворяют казеин, разжижают
желатин, свертывают молоко, образуют индол, аммиак,
сероводород, восстанавливают нитраты в нитриты
• Образуют ферменты: гиалуронидазу, ДНК-азу,
плазмокоагулазу (S.aureus), лецитиназу, фосфатазу, уреазу,
β- лактамазы, фибринолизин
• Образуют токсины: гемолизины (мембранотоксины),
лейкоцидин (разрушает нейтрофилы), некротоксин (некроз
кожи), эксфолиатины (поражают кожные покровы у детей),
токсин синдрома токсического шока, энтеротоксины
(пищевые отравления), летальный токсин
9
10.
Антигенные свойства• около 50 типов Аг: белковые, пептидогликан,
токсины,
• видоспецифические антигены - тейхоевые
кислоты, белок А
10
11.
ЭпидемиологияИсточник инфекции: носители (нос, зев, кожа) и
больные люди, эндогенная инфекция
Пути передачи: контактно-бытовой, воздушнокапельный, воздушно-пылевой, пищевой
(пищевые интоксикации)
11
12.
13.
14.
Основные инфекции человека, вызываемыепатогенными стафилококками
14
15.
Микробиологическая диагностика• Цель: выделение и идентификация стафилококков
• Материал: гной, слизь из носа и зева, мокрота,
моча, дуоденальное содержимое, кровь, рвотные
массы
• Основные методы исследования:
Микроскопический (мазок и окраска по Граму)
Микробиологический (изучение комплекса биологических
свойств)
Биологический (чувствительность экспериментальных
животных)
15
16.
Микробиологическая диагностикаI этап. Цель: получение изолированных колоний
по Граму
37°C
исследуемый материал
18-24 ч.
питательная среда
I этап. Цель: накопление чистой культуры
37°C
18-24 ч
16
17.
Микробиологическая диагностикаIII этап. Цель: идентификация исследуемой культуры
t
по Граму
«Пестрый ряд»
t
РА с диагностич.
t
t
реакция фаголизиса
метод дисков
сыворотками
37°C
18-24 ч.
37°C
18-24 ч.
37°C
18-24 ч.
17
IV этап. Учет результатов. Выдача ответа
37°C 18-24 ч.
18.
Микробиологическая диагностикастафилококков
1 день
1. Ориентировочная бактериоскопия (окраска по Граму: гроздьевидные
скопления грам(+) кокков)
2. Посев на желточно-солевой агар и кровяной агар с целью получения
изолированных колоний
2 день
1. Изучение культуральных свойств (мутные круглые ровные колонии
средних размеров кремового, желтого или оранжевого цвета)
ЖСА: при наличии лецитиназы вокруг колоний образуются зоны
помутнения с перламутровым оттенком (опалесценция);
Кровяной агар: при наличии гемолизина вокруг колоний образуются
зоны α- и ß-гемолиза;
2. Приготовление мазка, окраска по Граму и изучение морфологических и
тинкториальных свойств: гроздьевидные скопления грам(+) кокков
3. Пересев на скошенный агар с целью получения чистой культуры
18
19.
Микробиологическая диагностикастафилококков
3-4 день
1. Определение чистоты выделенной чистой культуры макроскопически и
микроскопически
2. Идентификация выделенной чистой культуры по
морфологическим и тинкториальным свойствам: гроздьевидные скопления
грам(+) кокков
культуральным свойствам: мутные круглые ровные колонии средних размеров
кремового, желтого или оранжевого цвета (признаком патогенности
стафилококков является образование золотистого или желто-лимонного
пигмента
биохимическим свойствам (см.табл 2)
факторам патогенности (наличие плазмокоагулазы, лецитиназы, гемолизина и
др.)
фаготипу (фагоидентификация)
3. Определение чувствительности выделенной чистой культуры к антибактериальным
препаратам. Особое значение для идентификации стафилококков с высокими
вирулентными свойствами и множественной устойчивостью к антибиотикам
19
имеет оценка резистентности к метициллину (MRSA-стафилококки
20.
Лечение и профилактикаЛечение. Антибиотиками
(Антибиотикочуствительность!!!)
β-лактамные антибиотики (бензилпенициллин,
цефалоспорины), препараты резерва: карбопенемы,
линкомицин, ванкомицин,
бактериофаги, антистафилококковый иммноглобулин,
антифагин (вакцина стафилококковая лечебная).
Профилактика – специфическая (иммунизация
стафилококковым анатоксином, профилактика
пиодермий) и неспецифическая: устранение
витаминной недостаточности, соблюдение санитарноэпидемиологического режима в ЛПУ, аптеках, на
объектах пищевой промышленности.
20
21.
Спасибо за внимание!Наши контакты:
117105, г. Москва, Варшавское шоссе, д. 16А
тел.: 8 (499)418-00-02 e-mail: mkramn@inbox.ru
www.mkramn.ru

medicine
medicine








